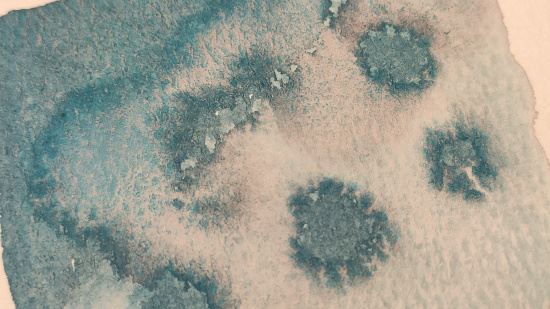

Описание
140 руб.
126 руб.
Скидка 10%
В корзину
В избранное
Характеристики
|
Производитель
|
Невская Палитра |
|
Номер
|
561 |
|
Объем
|
2,5мл |
|
Применение
|
Материал для акварели |
|
Серия
|
Белые ночи |
|
Подкатегория
|
Акварель |
|
Категория
|
Краски |
|
Производитель
|
Невская Палитра |
|
Номер
|
561 |
|
Объем
|
2,5мл |
|
Применение
|
Материал для акварели |
|
Серия
|
Белые ночи |
|
Подкатегория
|
Акварель |
|
Категория
|
Краски |
Описание
Характеристики
|
Производитель
|
Невская Палитра |
|
Номер
|
561 |
|
Объем
|
2,5мл |
|
Применение
|
Материал для акварели |
|
Серия
|
Белые ночи |
|
Подкатегория
|
Акварель |
|
Категория
|
Краски |